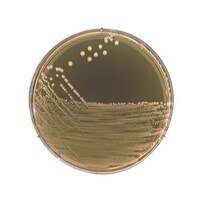
�l���������@���̂c�w�@���T�O�~�����P�W�O�~�����U�T�@�����@�s�a�P�O�T�@�P��

FUSO ディープタイプ/深刺プローブ
+もっと見る
オムロン 整体DX 幅50×長さ180×高さ65 抹茶 TB105 1台
胴体長40mm、角胴シリーズ小形で、しかも切れ味の良いソフトな動作感触。パネルへの取りつけは前面からワンタッチ、ランプ交換もツールレスで簡単。
胴体長40mm、角胴シリーズ小形で、しかも切れ味の良いソフトな動作感触。パネルへの取りつけは前面からワンタッチ、ランプ交換もツールレスで簡単。+もっと見る
EYELA 温度調節器(サーモコントローラー)
+もっと見る
ユニオンツール ロングネックスクエア
+もっと見る
オムロン 整体DX 幅50×長さ180×高さ65 抹茶 TB105 1台
ユニットの取り外しはレバーで簡単に着脱可能。スイッチ部3列取りつけで、配線効率をアップ。フィンガープロテクト付のスイッチ部を標準装備。φ25用リングの使用によってφ25のパネルカットにも対応。
ユニットの取り外しはレバーで簡単に着脱可能。スイッチ部3列取りつけで、配線効率をアップ。フィンガープロテクト付のスイッチ部を標準装備。φ25用リングの使用によってφ25のパネルカットにも対応。+もっと見る
テラモト 整体DX 幅50×長さ180×高さ65 抹茶 TB105 1台
軽量で入れ替え簡単なアルミフレーム付ポスターパネルです。差し込むだけでベルトパーテーションに取り付けられます。この商品は屋内用です。屋外には設置しないでください。
軽量で入れ替え簡単なアルミフレーム付ポスターパネルです。差し込むだけでベルトパーテーションに取り付けられます。この商品は屋内用です。屋外には設置しないでください。+もっと見る
オムロン 整体DX 幅50×長さ180×高さ65 抹茶 TB105 1台
ユニットの取り外しはレバーで簡単に着脱可能。スイッチ部3列取りつけで、配線効率をアップ。フィンガープロテクト付のスイッチ部を標準装備。φ25用リングの使用によってφ25のパネルカットにも対応。
ユニットの取り外しはレバーで簡単に着脱可能。スイッチ部3列取りつけで、配線効率をアップ。フィンガープロテクト付のスイッチ部を標準装備。φ25用リングの使用によってφ25のパネルカットにも対応。+もっと見る
オムロン 整体DX 幅50×長さ180×高さ65 抹茶 TB105 1台
ユニットの取り外しはレバーで簡単に着脱可能。スイッチ部3列取りつけで、配線効率をアップ。フィンガープロテクト付のスイッチ部を標準装備。φ25用リングの使用によってφ25のパネルカットにも対応。
ユニットの取り外しはレバーで簡単に着脱可能。スイッチ部3列取りつけで、配線効率をアップ。フィンガープロテクト付のスイッチ部を標準装備。φ25用リングの使用によってφ25のパネルカットにも対応。+もっと見る